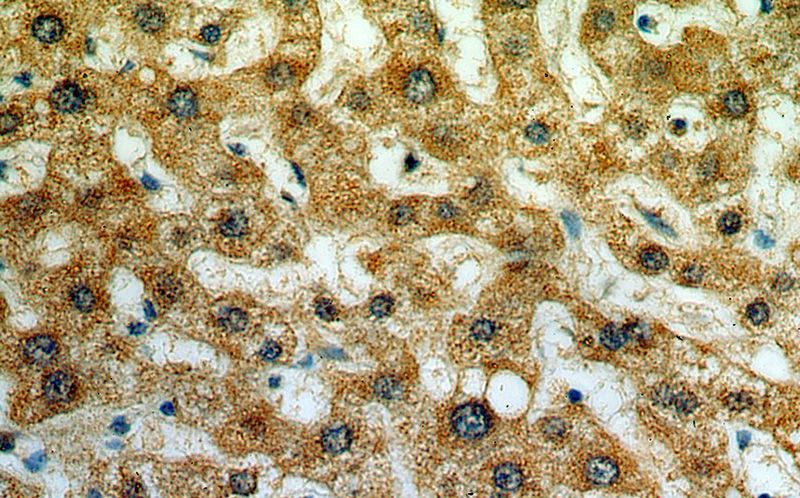
Immunohistochemical of paraffin-embedded human liver using Catalog No:113119(NEU4 antibody) at dilution of 1:50 (under 40x lens)

-
Product Name
NEU4 antibody
- Documents
-
Description
NEU4 Rabbit Polyclonal antibody. Positive WB detected in L02 cells. Positive IP detected in L02 cells. Positive IHC detected in human liver tissue. Observed molecular weight by Western-blot: 52-55 kDa
-
Tested applications
ELISA, IHC, WB, IP
-
Species reactivity
Human; other species not tested.
-
Alternative names
N acetyl alpha neuraminidase 4 antibody; NEU4 antibody; sialidase 4 antibody
- Immunogen
-
Isotype
Rabbit IgG
-
Preparation
This antibody was obtained by immunization of NEU4 recombinant protein (Accession Number: NM_080741). Purification method: Antigen affinity purified.
-
Clonality
Polyclonal
-
Formulation
PBS with 0.1% sodium azide and 50% glycerol pH 7.3.
-
Storage instructions
Store at -20℃. DO NOT ALIQUOT
-
Applications
Recommended Dilution:
WB: 1:500-1:5000
IP: 1:200-1:2000
IHC: 1:20-1:200
-
Validations

Immunohistochemical of paraffin-embedded human liver using Catalog No:113119(NEU4 antibody) at dilution of 1:50 (under 10x lens)
Immunohistochemical of paraffin-embedded human liver using Catalog No:113119(NEU4 antibody) at dilution of 1:50 (under 40x lens)

L02 cells were subjected to SDS PAGE followed by western blot with Catalog No:113119(NEU4 Antibody) at dilution of 1:1000

IP Result of anti-NEU4 (IP:Catalog No:113119, 4ug; Detection:Catalog No:113119 1:500) with L02 cells lysate 1400ug.
-
Background
NEU4, also named as LP5125, belongs to a family of glycohydrolytic enzymes, which remove terminal sialic acid residues from various sialo derivatives, such as glycoproteins, glycolipids, oligosaccharides, and gangliosides. It may function in lysosomal catabolism of sialylated glycoconjugates. NEU4 has a broad substrate specificity being active on glycoproteins, oligosaccharides and sialylated glycolipids.
-
References
- Jayanth P, Amith SR, Gee K, Szewczuk MR. Neu1 sialidase and matrix metalloproteinase-9 cross-talk is essential for neurotrophin activation of Trk receptors and cellular signaling. Cellular signalling. 22(8):1193-205. 2010.
- Amith SR, Jayanth P, Franchuk S. Dependence of pathogen molecule-induced toll-like receptor activation and cell function on Neu1 sialidase. Glycoconjugate journal. 26(9):1197-212. 2009.
- Finlay TM, Jayanth P, Amith SR. Thymoquinone from nutraceutical black cumin oil activates Neu4 sialidase in live macrophage, dendritic, and normal and type I sialidosis human fibroblast cells via GPCR Galphai proteins and matrix metalloproteinase-9. Glycoconjugate journal. 27(3):329-48. 2010.
- Finlay TM, Abdulkhalek S, Gilmour A. Thymoquinone-induced Neu4 sialidase activates NFκB in macrophage cells and pro-inflammatory cytokines in vivo. Glycoconjugate journal. 27(6):583-600. 2010.
- Bilyy RO, Shkandina T, Tomin A. Macrophages discriminate glycosylation patterns of apoptotic cell-derived microparticles. The Journal of biological chemistry. 287(1):496-503. 2012.
- Gilmour AM, Abdulkhalek S, Cheng TS. A novel epidermal growth factor receptor-signaling platform and its targeted translation in pancreatic cancer. Cellular signalling. 25(12):2587-603. 2013.
- Alghamdi F, Guo M, Abdulkhalek S, Crawford N, Amith SR, Szewczuk MR. A novel insulin receptor-signaling platform and its link to insulin resistance and type 2 diabetes. Cellular signalling. 26(6):1355-68. 2014.
Related Products / Services
Please note: All products are "FOR RESEARCH USE ONLY AND ARE NOT INTENDED FOR DIAGNOSTIC OR THERAPEUTIC USE"
